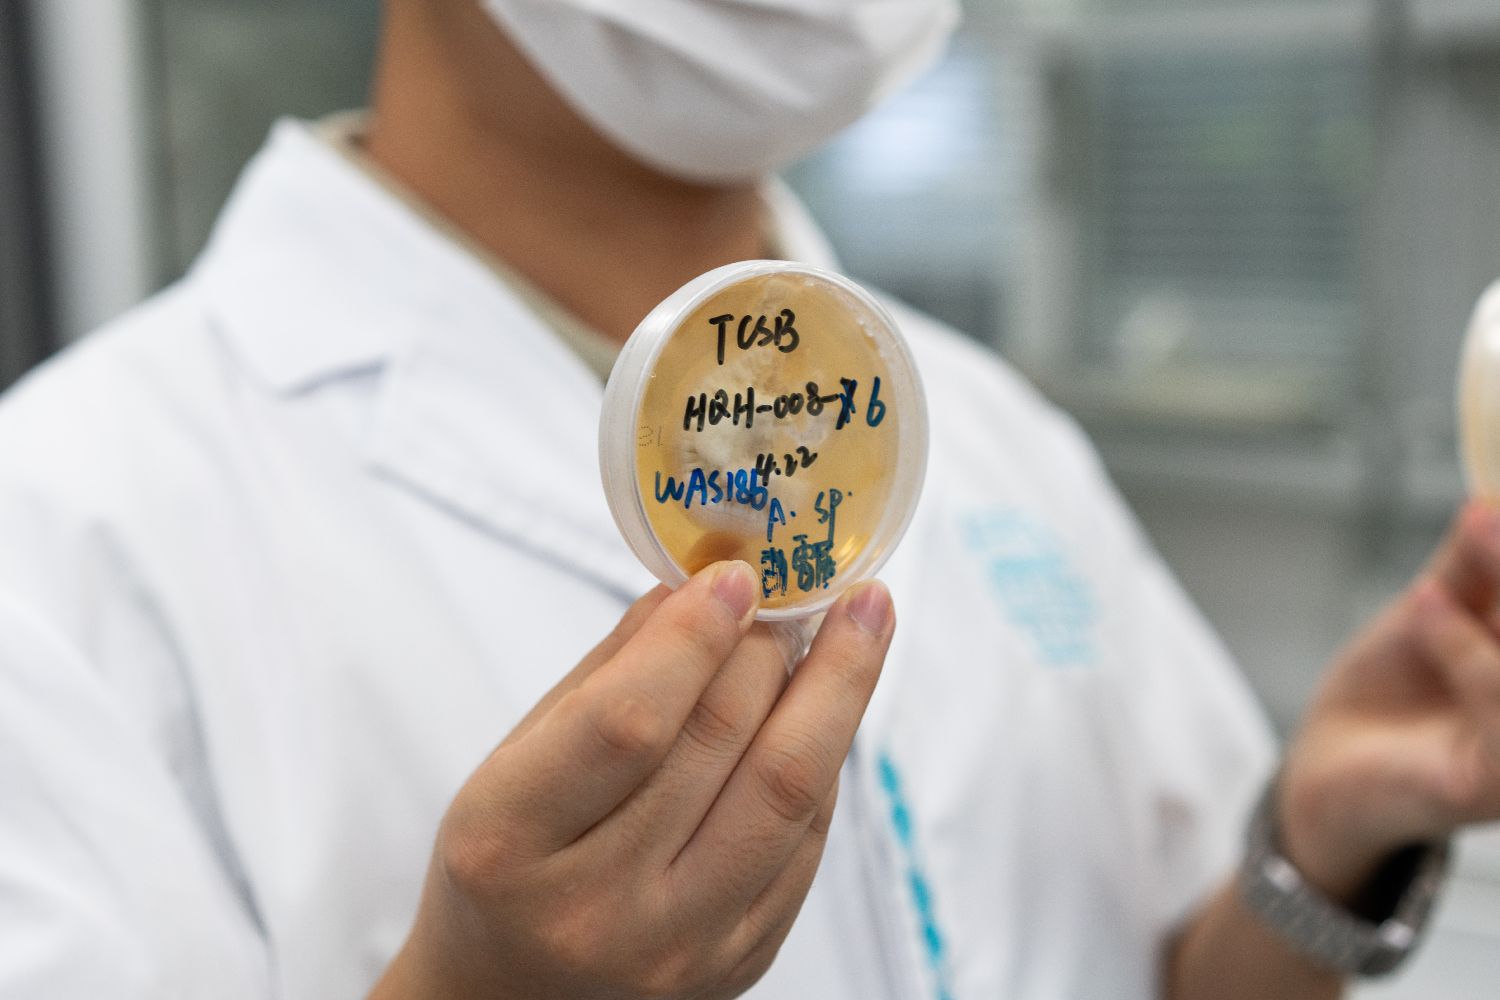

书画、漆器、皮革类、纺织品等有机质文物易受保存环境中的光线、温度、湿度等物理因素影响,因害虫和微生物导致文物的生物劣化,也常困扰文物保护工作者。
中新社25日从重庆中国三峡博物馆获悉,该馆科研团队开展的“馆藏文物虫霉病害防治研究”项目正为业内文物虫霉病害防治提供创新方案,多项研究系“中国唯一”,相关成果已服务中国全国50余家文博单位。
“这是一项积累了30多年探索的研究。”重庆中国三峡博物馆文物保护与考古部副主任唐欢介绍,重庆既是“雾都”又是“火炉”,湿热环境使文物很容易长霉、生虫。从20世纪90年代起,该馆文保工作者就向虫霉病害发起“挑战”,为馆藏文物生物病害防治科学研究奠定了坚实基础。
重庆中国三峡博物馆文物保护与考古部工作人员展示从文物上采集的霉变样本。(图片来源:本文图片均来自中新社)
面对业内文物虫霉病害防治专业人员匮乏的问题,重庆中国三峡博物馆还组建了一支“既懂生物又懂文物”的复合型研究队伍,半数以上的“90后”青年来自理工农医等多个学科。
“我是学习农药学的,没想到所学能应用于文保领域。”毕业于西南大学的刘家路博士称,其最大的变化是把研究虫的工作从农田搬至博物馆。霉变主要由真菌引起,而虫害是文物本体及其环境中存在的虫源直接导致的,为摸清虫霉病害的“家底”,入职三年多,他和团队已到中国60余家文博机构“寻菌捉虫”。
基于来自中国各地的虫霉病害数据资源,重庆中国三峡博物馆成功建立中国唯一的馆藏文物生物病害致病菌种库和虫种库,涵盖真菌182种、害虫8种、病害图片8000余张,为虫霉病害消杀效果评估提供指示菌和指示虫。结合卷积神经网络算法,团队还搭建了中国首个文物常见生物病害在线专家系统。通过图片和序列上传比对,实现馆藏文物生物病害快速识别,极大提升了缺乏生物背景知识的基层文物保管人员对文物虫霉病害风险的感知和管理能力。

重庆中国三峡博物馆文物保护与考古部工作人员展示采集到的虫种。
据悉,文物霉变和虫蛀一旦被肉眼发现时,往往已经十分严重,为后续的保护修复带来极大困难。生物化学与分子生物学专业博士覃丹介绍,除了馆藏文物生物劣化机制研究、数据库建设,团队近年来还通过研发植物源熏蒸剂与装备,实现馆藏文物生物病害防治技术的原创性突破。
“植物精油因其天然的抗虫和抗霉特性,常被用于农业、日化、医药等领域,这启发了我们。”覃丹说,团队通过查阅文献,筛选出上百种可能对文物虫霉病害防治有效的植物提取精油,在反复测试和优化后,成功调配出10余种高效、安全并适用于环境消杀的植物源熏蒸剂配方。此外,团队原创设计的最新版本熏蒸器内设传感器,能自动感应环境温度和湿度,当温度和湿度超过一定阈值时,熏蒸器会自动启动,确保文物保存环境的适宜。
“目前,团队科研成果辐射范围涵盖湿热多雨、霉虫高发的南方地区以及寒冷干燥的西北地区,极大地拓宽了研究成果的应用场景和适用区域。”唐欢表示,从微观到宏观,从基础理论到应用实践,虽然“馆藏文物虫霉病害防治研究”的维度众多,但文保工作者“服务文物保护需求”的初心不会改变。
(编辑:夏莹)

